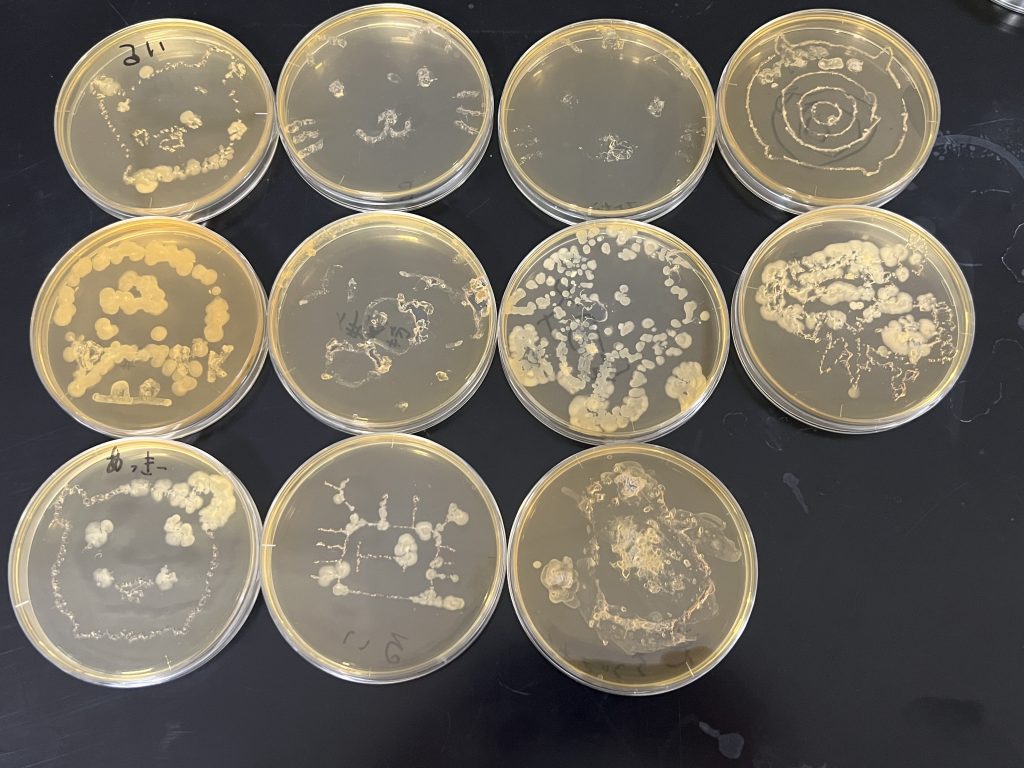
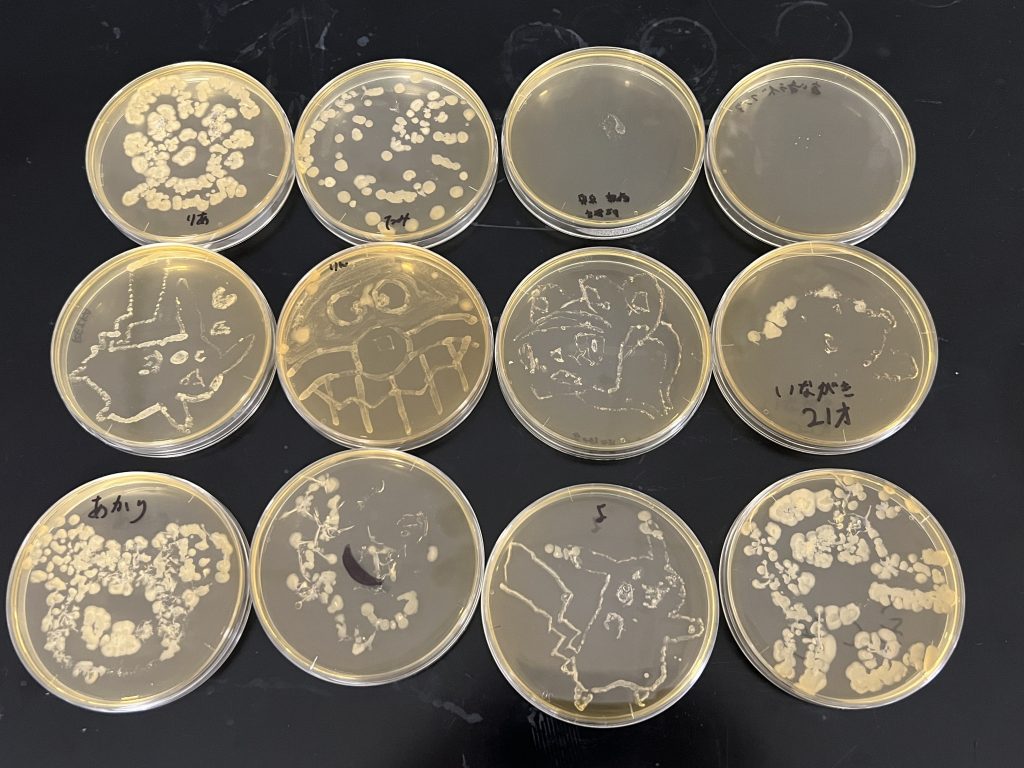
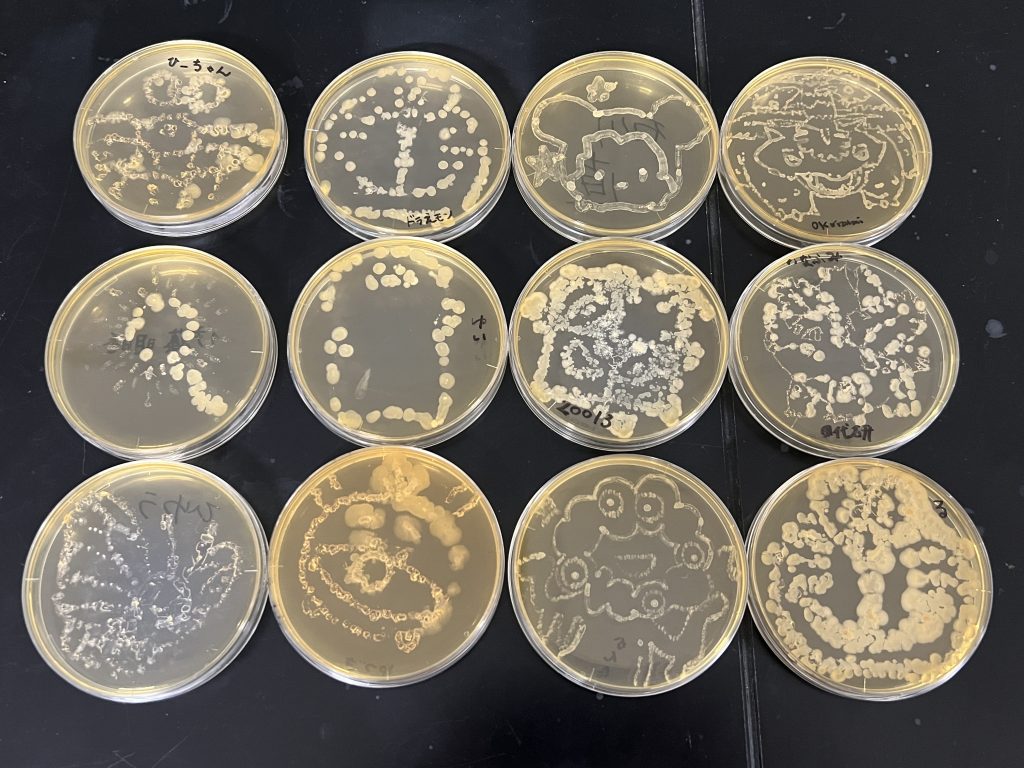
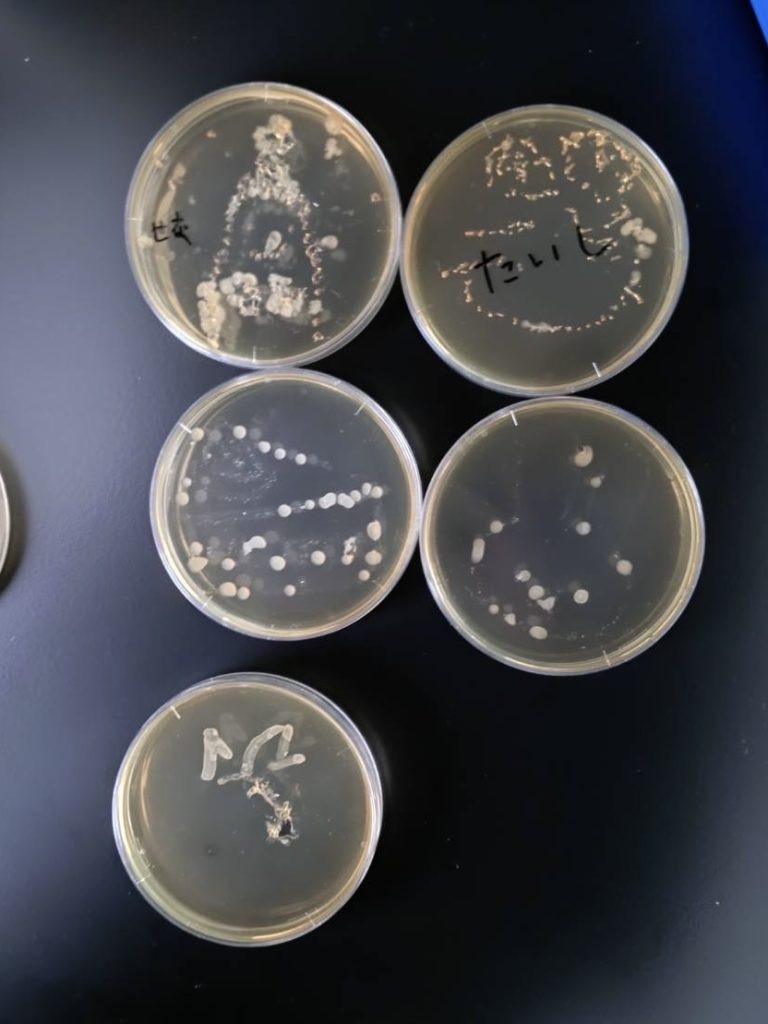
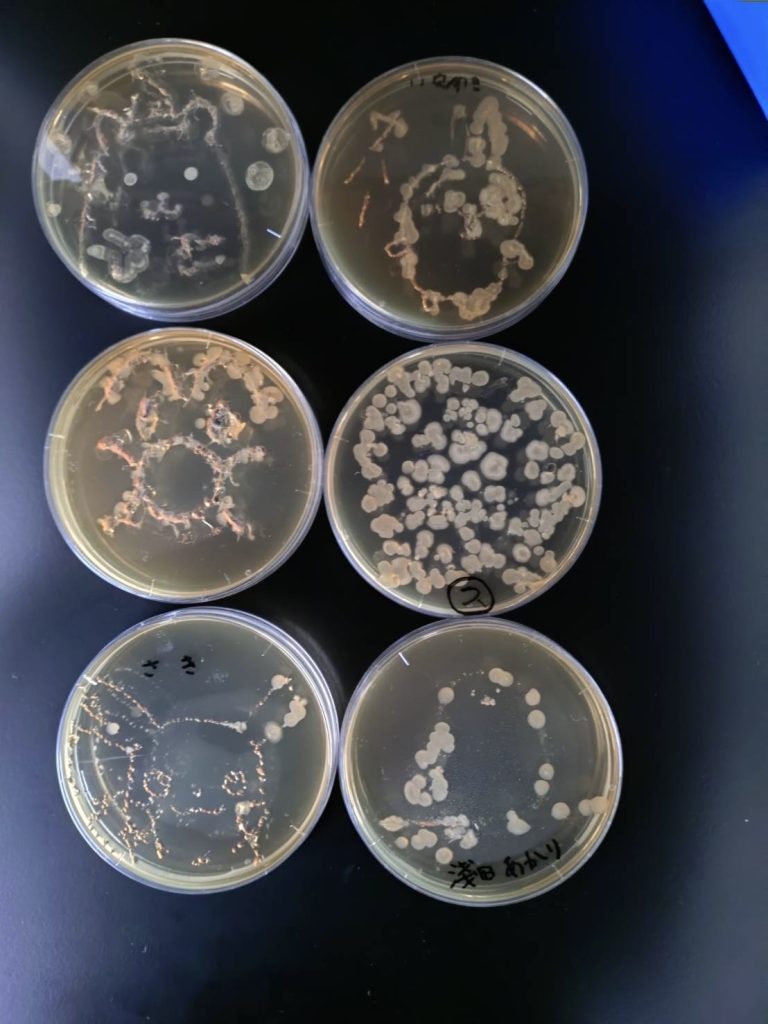
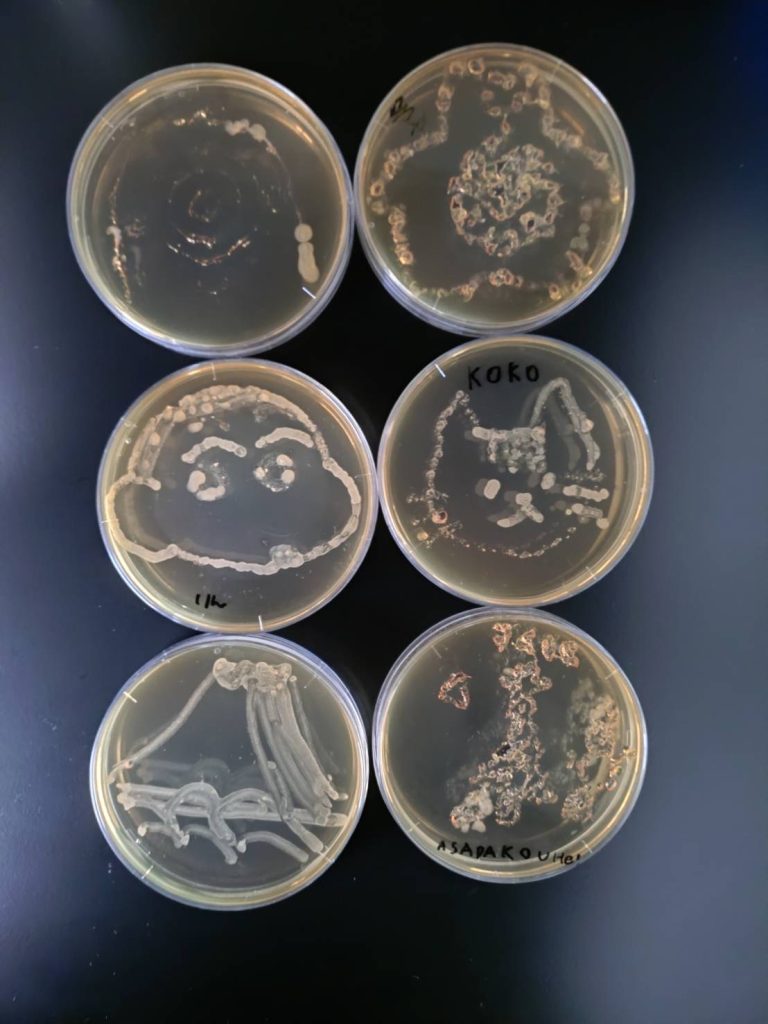
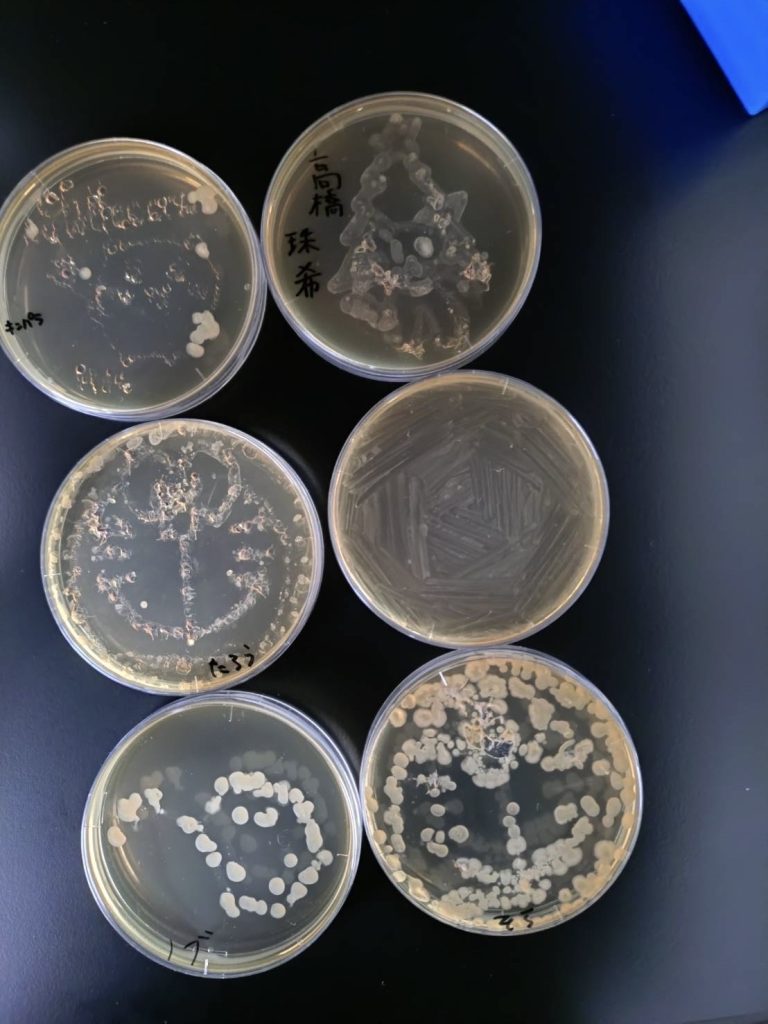

2025年11月8-9日に静大テクノフェスタがあり、バイオ系研究室で「美生物を見よう!」を開催しました。
来場者に微生物アートを体験してもらいました!まずは11月8日(土)に描いてもらった作品です。
来場してくださった方ありがとうございました!

11月9日(日)にも多くの方にご来場いただきました。ありがとうございました。

Department of Applied Chemistry and Biochemical Engineering, Faculty of Engineering, Shizuoka University